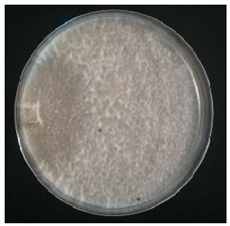
Conservation 05 00070 i001
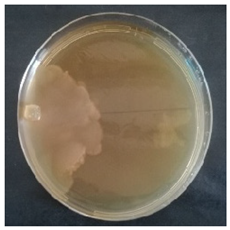
Conservation 05 00070 i004
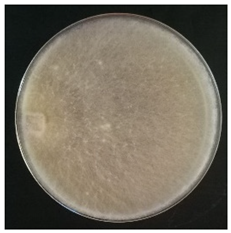
Conservation 05 00070 i009

Culture Collections for Conservation Ex Situ: Characterization and Biotechnological Application Potential of Saprotrophic Fungal Strains from Brazil
Abstract
1. Introduction
2. Materials and Methods
2.1. Sampling and Isolation
2.2. Identification
2.3. Distribution
2.4. Culture Characterization
3. Results
4. Discussion
5. Conclusions
Author Contributions
Funding
Data Availability Statement
Acknowledgments
Conflicts of Interest
References
- Varese, G.C.; Angelini, P.; Bencivenga, M.; Buzzini, P.; Donnini, D.; Gargano, M.L.; Maggi, O.; Pecoraro, L.; Persiani, A.M.; Savino, E.; et al. Ex situ conservation and exploitation of fungi in Italy. Plant Biosyst. 2011, 145, 997–1005. [Google Scholar] [CrossRef]
- Gargano, M.L. Mycotheca of edible and medicinal mushrooms at herbarium SAF as a potential source of nutraceuticals and cultivated mushrooms. Int. J. Med. Mushrooms 2018, 20, 405–409. [Google Scholar] [CrossRef] [PubMed]
- Girometta, C.E.; Bernicchia, A.; Baiguera, R.M.; Bracco, F.; Buratti, S.; Cartabia, M.; Picco, A.M.; Savino, E. An Italian research culture collection of wood decay fungi. Diversity 2020, 12, 58. [Google Scholar] [CrossRef]
- Cartabia, M.; Girometta, C.E.; Baiguera, R.M.; Buratti, S.; Babbini, S.; Bernicchia, A.; Savino, E. Lignicolous fungi collected in Northern Italy: Identification and morphological description of isolates. Diversity 2022, 14, 413. [Google Scholar] [CrossRef]
- WFCC: World Federation for Culture Collections. Available online: https://wfcc.info/ (accessed on 18 November 2023).
- MIRRI: Microbial Resource Research Infrastructure. Available online: https://www.mirri.org/ (accessed on 18 November 2023).
- Mueller, G.M.; Cunha, K.M.; May, T.W.; Allen, J.L.; Westrip, J.R.; Canteiro, C.; Costa-Rezende, D.H.; Drechsler-Santos, E.R.; Vasco-Palacios, A.M.; Ainsworth, A.M.; et al. What do the first 597 Global Fungal Red List assessments tell us about the threat status of fungi? Diversity 2022, 14, 736. [Google Scholar] [CrossRef]
- Schoch, C.L.; Seifert, K.A.; Huhndorf, S.; White, M.M. Nuclear ribosomal internal transcribed spacer (ITS) region as a universal DNA barcode marker for Fungi. Proc. Natl. Acad. Sci. USA 2012, 109, 6241–6246. [Google Scholar] [CrossRef]
- Nilsson, R.H.; Ryberg, M.; Kristiansson, E.; Abarenkov, K.; Larsson, K.H.; Kõljalg, U. Taxonomic reliability of DNA sequences in public sequence databases: A fungal perspective. PLoS ONE 2006, 1, e59. [Google Scholar] [CrossRef]
- Dresch, P.; Rosam, K.; Grienke, U.; Rollinger, J.M.; Peintner, U. Fungal strain matters: Colony growth and bioactivity of the European medicinal polypores Fomes fomentarius, Fomitopsis pinicola and Piptoporus betulinus. AMB Express 2015, 5, 4. [Google Scholar] [CrossRef]
- Peay, K.G.; Bidartondo, M.I.; Arnold, A.E. Not every fungus is everywhere: Scaling to the biogeography of fungal–plant interactions across roots, shoots and ecosystems. New Phytol. 2010, 185, 878–882. [Google Scholar] [CrossRef]
- Ubaldi, D. Guida Allo Studio Della Flora e Della Vegetazione; CLUEB: Bologna, Italy, 2012. [Google Scholar]
- Ryvarden, L. African polypores—A review. Belg. J. Bot. 1998, 131, 150–155. [Google Scholar]
- Ryvarden, L. Studies in Neotropical polypores 43. Some new species from tropical America. Synop. Fungorum 2016, 35, 43–47. [Google Scholar]
- Decock, C.; Figueroa, S.H.; Robledo, G.; Castillo, G. Fomitiporia punctata (Basidiomycota, Hymenochaetales) and its presumed taxonomic synonyms in America: Taxonomy and phylogeny of some species from tropical/subtropical areas. Mycologia 2007, 99, 733–752. [Google Scholar] [CrossRef]
- Decock, C.A.; Ryvarden, L.; Amalfi, M. Niveoporofomes (Basidiomycota, Fomitopsidaceae) in Tropical Africa: Two additions from Afromontane forests, Niveoporofomes oboensis sp. nov. and N. widdringtoniae comb. nov. and N. globosporus comb. nov. from the Neotropics. Mycol. Prog. 2022, 21, 29. [Google Scholar] [CrossRef]
- Amalfi, M.; Yombiyeni, P.; Decock, C. Fomitiporia in sub-Saharan Africa: Morphology and multigene phylogenetic analysis support three new species from the Guineo-Congolian rainforest. Mycologia 2010, 102, 1303–1317. [Google Scholar] [CrossRef] [PubMed]
- Stamets, P. Growing Gourmet and Medicinal Mushrooms; Ten Speed Press: Berkeley, CA, USA, 2011. [Google Scholar]
- Okino, L.K.; Gomes Machado, K.M.; Fabris, C.; Ramos Bononi, V.L. Ligninolytic activity of tropical rainforest basidiomycetes. World J. Microbiol. Biotechnol. 2000, 16, 889–893. [Google Scholar] [CrossRef]
- Maziero, R.; Cavazzoni, V.; Ramos Bononi, V.L. Screening of basidiomycetes for the production of exopolysaccharide and biomass in submerged culture. Rev. Microbiol. 1999, 30, 77–84. [Google Scholar] [CrossRef]
- Da Silva, M.; Ribeiri de Oliveira, D. The new Brazilian legislation on access to the biodiversity (Law 13,123/15 and Decree 8772/16). Braz. J. Microbiol. 2018, 49, 1–4. [Google Scholar] [CrossRef]
- Mycobank Molecular ID. Available online: https://www.mycobank.org/Pairwise_alignment (accessed on 18 November 2024).
- BLAST: Basic Local Alignment Search Tool—NCBI. Available online: https://blast.ncbi.nlm.nih.gov/Blast.cgi (accessed on 17 June 2025).
- GenBank NCBI. Available online: https://www.ncbi.nlm.nih.gov/genbank (accessed on 17 June 2025).
- IBGE: Instituto Brasileiro de Geografia e Estatística. Available online: https://www.ibge.gov.br/en/home-eng.html?lang=en-GB (accessed on 21 June 2025).
- Sano, E.E.; Rodrigues, A.A.; Martins, E.S.; Bettiol, G.M.; Bustamante, M.M.; Bezerra, A.S.; Couto, A.C., Jr.; Vasconcelos, V.; Schüler, J.; Bolfe, E.L. Cerrado ecoregions: A spatial framework to assess and prioritize Brazilian savanna environmental diversity for conservation. J. Environ. Manag. 2019, 232, 818–828. [Google Scholar] [CrossRef]
- GBIF: Global Biodiversity Information Facility. Available online: https://www.gbif.org/occurrence/download/0104897-230530130749713 (accessed on 17 June 2025).
- Neotropical Fungi Archive. Available online: https://www.neotropicalfungi.com/ (accessed on 17 June 2025).
- Carta, A.; Peruzzi, L.; Ramìrez-Barahona, S. A global phylogenetic regionalization of vascular plants reveals a deep split between Gondwanan and Laurasian biotas. New Phytol. 2022, 233, 1494–1504. [Google Scholar] [CrossRef]
- Buratti, S.; Girometta, C.E.; Savino, E.; Gorjón, S.P. An example of the conservation of wood decay fungi: The new research culture collection of corticioid and polyporoid strains of the University of Salamanca (Spain). Forests 2023, 14, 2029. [Google Scholar] [CrossRef]
- Index Fungorum. Available online: www.indexfungorum.org (accessed on 17 June 2025).
- Mycobank Database. Available online: www.mycobank.org (accessed on 17 June 2025).
- Koike, Y.; Wada, K.; Kusano, G.; Nozoe, S.; Yokoyama, K. Isolation of psilocybin from Psilocybe argentipes and its determination in specimens of some mushrooms. J. Nat. Prod. 1981, 44, 362–365. [Google Scholar] [CrossRef]
- Liu, Y.P.; Dai, Q.; Wang, W.X.; He, J.; Li, Z.H.; Feng, T.; Liu, J.K. Psathyrins: Antibacterial diterpenoids from Psathyrella candolleana. J. Nat. Prod. 2020, 83, 1725–1729. [Google Scholar] [CrossRef]
- Wu, H.; Yang, H.X.; Li, Z.H.; Feng, T.; Liu, J.K. Psathyrellins A–E, antibacterial guanacastane diterpenoids from mushroom Psathyrella candolleana. Nat. Prod. Bioprospect 2021, 11, 447–452. [Google Scholar] [CrossRef]
- Karaltı, İ.; Eraslan, E.C.; Sarıdoğan, B.G.Ö.; Akata, I.; Sevindik, M. Total antioxidant, antimicrobial, antiproliferative potentials and element contents of wild mushroom Candolleomyces candolleanus (Agaricomycetes) from Turkey. Int. J. Med. Mushrooms 2022, 24, 69–76. [Google Scholar] [CrossRef] [PubMed]
- Al-Habib, M.N.; Holliday, J.; Aladahmy, M.S. Psathyrella candolleana and Agaricus bisporus extracts provide protection against DNA oxidative damage induced by doxorubicin. Int. J. Med. Mushrooms 2018, 20, 8. [Google Scholar] [CrossRef] [PubMed]
- Sivanandhan, S.; Ganesan, P.; David, R.H.A.; Paulraj, M.G.; Ignacimuthu, S. Mosquitocidal activity of the pale brittle stem mushroom, Psathyrella candolleana (Agaricomycetes), against three vector mosquitoes. Int. J. Med. Mushrooms 2019, 21, 725–734. [Google Scholar] [CrossRef] [PubMed]
- Al-Fatimi, M.; Wurster, M.; Kreisel, H.; Lindequist, U. Antimicrobial, cytotoxic and antioxidant activity of selected basidiomycetes from Yemen. Pharmazie 2005, 60, 776–780. [Google Scholar]
- Santos, G.S.; Peters, L.P.; Carvalho, C.M. Study of antibacterial activity of Amazonian Agaricomycetes mushrooms from Brazil. Int. J. Med. Mushrooms 2020, 22, 573–580. [Google Scholar] [CrossRef]
- Dona, M.P.S.M.; Deraniyagala, A.S.; Wijesinghe, P.; Attanayake, R.N. Molecular phylogeny of wood decay fungi of hardwood and their ability to produce laccase that correlates with triphenylmethane dye decolorization. BioRxiv 2019, 648147. [Google Scholar] [CrossRef]
- Liang, Y.; Lin, J.; Zheng, H.; Li, M.; Huang, F. Biological Characters of Cubamyces lactineus. Acta Edulis Fungi 2022, 29, 51–58. [Google Scholar]
- He, N.; Tian, L.; Zhai, X.; Zhang, X.; Zhao, Y. Composition characterization, antioxidant capacities and anti-proliferative effects of the polysaccharides isolated from Trametes lactinea (Berk.). Pat. Int. J. Biol. Macromol. 2018, 115, 114–123. [Google Scholar] [CrossRef]
- Hao, J.; Ye, L.; Meng, G.; Song, Y.; Fu, J.; Wu, X. The protective effect and crucial biological pathways analysis of Trametes lactinea mycelium polysaccharides on acute alcoholic liver injury in mice based on transcriptomics and metabonomics. Food Sci. Hum. Wellness 2021, 10, 480–489. [Google Scholar] [CrossRef]
- Zhang, Q.; Huang, N.; Wang, J.; Luo, H.; He, H.; Ding, M.; Deng, W.; Zou, K. The H+/K+-ATPase inhibitory activities of Trametenolic acid B from Trametes lactinea (Berk.) Pat, and its effects on gastric cancer cells. Fitoterapia 2013, 89, 210–217. [Google Scholar] [CrossRef] [PubMed]
- Awala, S.I.; Oyetayo, V.O. Assessment of free radical scavenging potentials of extracts of Trametes lactinea collected from Akure. Res. J. Phytochem. 2016, 10, 10–20. [Google Scholar] [CrossRef]
- Wang, J.; Wang, A.; He, H.; She, X.; He, Y.; Li, S.; Liu, L.; Luo, T.; Huang, N.; Luo, H.; et al. Trametenolic acid B protects against cerebral ischemia and reperfusion injury through modulation of microRNA-10a and PI3K/Akt/mTOR signaling pathways. Biomed. Pharmacother. 2019, 112, 108692. [Google Scholar] [CrossRef] [PubMed]
- Zawadzka, K.; Felczak, A.; Nowak, M.; Kowalczyk, A.; Piwoński, I.; Lisowska, K. Antimicrobial activity and toxicological risk assessment of silver nanoparticles synthesized using an eco-friendly method with Gloeophyllum striatum. J. Hazard. Mater. 2021, 418, 126316. [Google Scholar] [CrossRef]
- Faria, M.G.I.; Avelino, K.V.; Philadelpho, B.O.; dos Santos Bomfim, R.; do Valle, J.S.; Júnior, A.C.G.; Dragunski, D.C.; de Souza Ferreira, E.; de Souza, C.O.; Ferreira Ribeiro, C.D.; et al. Lithium bioaccumulation in Lentinus crinitus mycelia grown in media with different lithium sources and pH values. Environ. Sci. Pollut. Res. 2022, 29, 87519–87526. [Google Scholar] [CrossRef]
- Bertéli, M.B.D.; Barros, L.; Reis, F.S.; Ferreira, I.C.; Glamočlija, J.; Soković, M.; Silveira do Valle, J.; Linde, G.A.; Ruiz, S.P.; Colauto, N.B. Antimicrobial activity, chemical composition and cytotoxicity of Lentinus crinitus basidiocarp. Food Funct. 2021, 12, 6780–6792. [Google Scholar] [CrossRef]
- Bertéli, M.B.; Oliveira Filho, O.B.; Freitas, J.D.; Bortolucci, W.C.; Silva, G.R.; Gazim, Z.C.; Lívero, F.A.R.; Lovato, E.C.W.; Silveira do Valle, J.; Linde, G.A.; et al. Lentinus crinitus basidiocarp stipe and pileus: Chemical composition, cytotoxicity and antioxidant activity. Eur. Food Res. Technol. 2021, 247, 1355–1366. [Google Scholar] [CrossRef]
- López-Legarda, X.; Arboleda-Echavarría, C.; Parra-Saldívar, R.; Rostro-Alanis, M.; Alzate, J.F.; Villa-Pulgarín, J.A.; Segura-Sánchez, F. Biotechnological production, characterization and in vitro antitumor activity of polysaccharides from a native strain of Lentinus crinitus. Int. J. Biol. Macromol. 2020, 164, 3133–3144. [Google Scholar] [CrossRef]
- Dulay, R.M.R.; Cabalar, A.C.; De Roxas, M.J.B.; Concepcion, J.M.P.; Cruz, N.E.; Esmeralda, M.; Jimenez, N.; Aguilar, J.C.; De Guzman, E.J.; Santiago, J.Q.; et al. Proximate composition and antioxidant activity of Panaeolus antillarium, a wild coprophilous mushroom. Curr. Res. Environ. Appl. 2015, 5, 52–59. [Google Scholar] [CrossRef]
- Gotvaldová, K.; Hájková, K.; Borovička, J.; Jurok, R.; Cihlářová, P.; Kuchař, M. Stability of psilocybin and its four analogs in the biomass of the psychotropic mushroom Psilocybe cubensis. Drug Test. Anal. 2021, 13, 439–446. [Google Scholar] [CrossRef]
- Nkadimeng, S.M.; Steinmann, C.M.; Eloff, J.N. Effects and safety of Psilocybe cubensis and Panaeolus cyanescens magic mushroom extracts on endothelin-1-induced hypertrophy and cell injury in cardiomyocytes. Sci. Rep. 2020, 10, 22314. [Google Scholar] [CrossRef]
- Zulfadhly, Z.; Mashitah, M.D.; Bhatia, S. Heavy metals removal in fixed-bed column by the macro fungus Pycnoporus sanguineus. Environ. Pollut. 2001, 112, 463–470. [Google Scholar] [CrossRef] [PubMed]
- Zhang, M.; Yan, M.; Yang, J.; Li, F.; Wang, Y.; Feng, K.; Wang, S.; Lin, N.; Wang, Y.; Yang, B. Structural characterization of a polysaccharide from Trametes sanguinea Lloyd with immune-enhancing activity via activation of TLR4. Int. J. Biol. Macromol. 2022, 206, 1026–1038. [Google Scholar] [CrossRef] [PubMed]
- Yan, M.; Zhang, M.; Zhu, Z.; Zhang, J.; Cheng, G.; Lin, N.; Zhao, H.; Yang, B. Structural characterization and tumor microvascular inhibition activity of total polysaccharide from Trametes sanguinea Lloyd. Chem. Biodivers. 2022, 19, e202100765. [Google Scholar] [CrossRef] [PubMed]
- Shen, C.; Yang, B.; Huang, L.; Chen, Y.; Zhao, H.; Zhu, Z. Cardioprotective effect of crude polysaccharide fermented by Trametes sanguinea Lyoyd on doxorubicin-induced myocardial injury mice. BMC Pharmacol. Toxicol. 2023, 24, 1. [Google Scholar]
- Jović, J.; Buntić, A.; Radovanović, N.; Petrović, B.; Mojović, L. Lignin-degrading abilities of novel autochthonous fungal isolates Trametes hirsuta F13 and Stereum gausapatum F28. Food Technol. Biotechnol. 2018, 56, 354. [Google Scholar] [CrossRef]
- Ortiz-Monsalve, S.; Valente, P.; Poll, E.; Jaramillo-García, V.; Henriques, J.A.P.; Gutterres, M. Biodecolourization and biodetoxification of dye-containing wastewaters from leather dyeing by the native fungal strain Trametes villosa SCS-10. Biochem. Eng. J. 2019, 141, 19–28. [Google Scholar] [CrossRef]
- Ferreira-Silva, V.; Gusmão, N.B.D.; Gibertoni, T.B.; Silva, L.A.D.O.D. Trametes lactinea and T. villosa collected in Brazil are able to discolor indigo carmine. Acta Bot. Brasilica 2022, 36, 2021abb0356. [Google Scholar] [CrossRef]
- Stalpers, J.A. Identification of wood-inhabiting fungi in pure culture. In Studies in Mycology; CABI: Oxfordshire, UK, 1978; Volume 16, 248p. [Google Scholar]
- Bakshi, B.K.; Sehgal, H.S.; Singh, B. Culture diagnosis of Indian Polyporaceae I. Genus Polyporus. Indian For. Rec. 1969, 2, 205–244. [Google Scholar]
- Motato-Vásquez, V.; Pires, R.M.; Vitali, V.M.V.; Gugliotta, A.D.M. Cultural and ligninolytic activity studies of some polypores (Basidiomycota) from brazilian Atlantic Forest, São Paulo State, Brazil. Hoehnea 2016, 43, 289–300. [Google Scholar] [CrossRef][Green Version]
- Nobles, M.K. Studies in wood-inhabiting Hymenomycetes III. Stereum pini and species of Peniophora sect. coloratae on conifers in Canada. Can. J. Bot. 1956, 34, 104–130. [Google Scholar]
- Nakasone, K.K. Culture studies and identification of wood-inhabiting Corticiaceae and selected Hymenomycetes from North America. Mycol. Mem. 1990, 15, 1–412. [Google Scholar]
- CBS-KNAW Collections—Westerdijk Institute. Available online: https://wi.knaw.nl/Collection (accessed on 17 June 2025).
- Mut-Mycotheca Universitatis Taurinensis. Available online: https://www.tucc-database.unito.it/mut (accessed on 17 June 2025).
- BCCM/MUCL Agro-Food & Environmental Fungal Collection. Available online: https://bccm.belspo.be/about-us/bccm-mucl (accessed on 17 June 2025).
- LE-BIN Strains—All-Russian Collection of Microorganisms—VKM. Available online: http://www.vkm.ru/eCatalogue/LE-BIN.htm (accessed on 17 June 2025).
- CABI Bioscience. Available online: https://form.jotform.com/232901487583059 (accessed on 28 April 2025).
- Vlasák, J.; Kout, J. Tropical Trametes lactinea is widely distributed in the Eastern USA. Mycotaxon 2011, 115, 271–279. [Google Scholar] [CrossRef]
- Murrill, W.A. Some Philippine Polyporaceae. Bull. Torrey Bot. Club 1907, 34, 465–481. [Google Scholar] [CrossRef]
- Murrill, W.A. The Polyporaceae of North America: XIII. The described species of Bjerkandera, Trametes, and Coriolus. Bull. Torrey. Bot. Club. 1905, 32, 633–656. [Google Scholar] [CrossRef]
- Lücking, R.; Truong, B.V.; Huong, D.T.; Le, N.H.; Nguyen, Q.D.; Nguyen, V.D.; Von Raab-Straube, E.; Bollendorff, S.; Kim Govers, K.; Di Vincenzo, V. Caveats of fungal barcoding: A case study in Trametes s.lat. (Basidiomycota: Polyporales) in Vietnam reveals multiple issues with mislabelled reference sequences and calls for third-party annotations. Willdenowia 2020, 50, 383–403. [Google Scholar] [CrossRef]
- Zmitrovich, I.V.; Ezhov, O.N.; Wasser, S.P. A survey of species of genus Trametes Fr. (higher Basidiomycetes) with estimation of their medicinal source potential. Int. J. Med. Mushrooms 2012, 14, 307–319. [Google Scholar] [CrossRef]
- Justo, A.; Hibbett, D.S. Phylogenetic classification of Trametes (Basidiomycota, Polyporales) based on a five-marker dataset. Taxon 2011, 60, 1567–1583. [Google Scholar] [CrossRef]
- Téllez-Téllez, M.; Villegas, E.; Rodriguez, A.; Acosta-Urdapilleta, M.L.; O’Donovan, A.; Diaz-Godinez, G. Mycosphere essay 11: Fungi of Pycnoporus: Morphological and molecular identification, worldwide distribution and biotechnological potential. Mycosphere 2016, 7, 1500. [Google Scholar] [CrossRef]
- Martin, R.; Gazis, R.; Skaltsas, D.; Chaverri, P.; Hibbett, D. Unexpected diversity of basidiomycetous endophytes in sapwood and leaves of Hevea. Mycologia 2015, 107, 284–297. [Google Scholar] [CrossRef] [PubMed]
- Musatti, A.; Ficara, E.; Mapelli, C.; Sambusiti, C.; Rollini, M. Use of solid digeState for lignocellulolytic enzymes production through submerged fungal fermentation. J. Environ. Manag. 2017, 199, 1–6. [Google Scholar] [CrossRef]
- Bellucci, M.; Marazzi, F.; Fornaroli, R.; Musatti, A.; Turolla, A.; Visigalli, S.; Bargna, M.; Bergna, G.; Canziani, R.; Mezzanotte, V.; et al. Assessment of anammox, microalgae and white-rot fungi-based processes for the treatment of textile wastewater. PLoS ONE 2021, 16, e0247452. [Google Scholar] [CrossRef] [PubMed]
- Castorina, G.; Cappa, C.; Negrini, N.; Criscuoli, F.; Casiraghi, M.C.; Marti, A.; Rollini, M.; Consonni, G.; Erba, D. Characterization and nutritional valorization of agriculture waste corncobs from Italian maize landraces through the growth of medicinal mushrooms. Sci. Rep. 2023, 13, 21148. [Google Scholar] [CrossRef]
- Goppa, L.; Spano, M.; Baiguera, R.M.; Cartabia, M.; Rossi, P.; Mannina, L.; Savino, E. NMR-Based characterization of wood decay fungi as promising novel foods: Abortiporus biennis, Fomitopsis iberica and Stereum hirsutum mycelia as case studies. Foods 2023, 12, 2507. [Google Scholar] [CrossRef]
- Corana, F.; Cesaroni, V.; Mannucci, B.; Baiguera, R.M.; Picco, A.M.; Savino, E.; Ratto, D.; Perini, C.; Kawagishi, H.; Girometta, C.E.; et al. Array of metabolites in Italian Hericium erinaceus mycelium, primordium, and sporophore. Molecules 2019, 24, 3511. [Google Scholar] [CrossRef] [PubMed]
- Allen, J.W.; Merlin, M.D. Psychoactive mushroom use in Koh Samui and Koh Pha-Ngan. J. Ethnopharmacol. 1992, 35, 205–228. [Google Scholar] [CrossRef]
- Merlin, M.D.; Allen, J.W. Species identification and chemical analysis of psychoactive fungi in the Hawaiian Islands. J. Ethnopharmacol. 1993, 40, 21–40. [Google Scholar] [CrossRef]
- Guzmán, G.; Allen, J.W.; Gartz, J. A worldwide geographical distribution of the neurotropic fungi, analysis and discussion. Annali Civ. Mus. Rovereto 2000, 14, 189–270. [Google Scholar]
- Grimm, D.; Wösten, H.A. Mushroom cultivation in the circular economy. Appl. Microbiol. Biotechnol. 2018, 102, 7795–7803. [Google Scholar] [CrossRef]
- Meyer, V.; Basenko, E.Y.; Benz, J.P.; Braus, G.H.; Caddick, M.X.; Csukai, M.; de Vries, R.P.; Endy, D.; Frisvad, J.C.; Gunde-Cimerman, N.; et al. Growing a circular economy with fungal biotechnology: A white paper. Fungal Biol. Biotechnol. 2020, 7, 5. [Google Scholar] [CrossRef]
- Nalon, M.A.; Matsukuma, C.K.; Pavão, M.; Ivanauskas, N.M.; Kanashiro, M.M. Inventário da Cobertura Vegetal Nativa do Estado de São Paulo. São Paulo: SIMA/IPA 2022. Available online: https://indd.adobe.com/view/a5aba10f-0090-4109-ac1c-944c8260b1ff (accessed on 17 June 2025).
- Dib, V.; Nalon, M.A.; Amazonas, N.T.; Vidal, C.Y.; Ortiz-Rodríguez, I.A.; Daněk, J.; Formis de Oliveira, M.; Alberti, P.; da Silva, A.; Salomão Precinoto, R.; et al. Drivers of change in biodiversity and ecosystem services in the Cantareira System Protected Area: A prospective analysis of the implementation of public policies. Biota Neotrop. 2020, 20, e20190915. [Google Scholar] [CrossRef]
| DeFENS § | CCB * | CCIBt | Collection Date | Municipality | CCB Identification Species | Revised Identification | ITS Accession |
|---|---|---|---|---|---|---|---|
| 242 | 158 | 2495 | 23 September 1992 | Unknown | Trametes versicolor | Cerrena caperata | OR805456 |
| 222 | 175 | 2512 | 17 June 1992 | Mogi das Cruzes -SP | Pycnoporus sanguineus | Pycnoporus sanguineus | OR805459 |
| 142 | 177 | 2514 | 23 May 1992 | Assis-SP | Lenzites striatum | Gloeophyllum striatum | OR805453 |
| 162 | 187 | 2524 | 22 September 1992 | Jarinú-SP | Panaeolus papilionaceus | Panaeolus antillarum | OR805465 |
| 254 | 193 | 2530 | 21 September 1992 | Ribeirão Grande-SP | Tyromyces pseudolacteus | Cubamyces lactineus | OR805460 |
| 246 | 213 | 2550 | 24 October 1992 | São Paulo-SP | Trametes villosa | Trametes villosa | OR805457 |
| 221 | 224 | 2561 | 1 December 1992 | São Paulo-SP | Psilocybe subcubensis | Psilocybe cubensis | OR805468 |
| 218 | 259 | 2596 | 12 November 1992 | São Vicente-SP | Psiloc. castanella var. subhyperella | Candolleomyces candolleanus | OR805458 |
| 237 | 267 | 2604 | 12 November 1992 | São Vicente-SP | Stereum ostrea | Stereum gausapatum | OR805455 |
| 141 | 274 | 2611 | 10 December 1992 | São Vicente-SP | Lentinus zeyheri | Lentinus crinitus | OR805452 |
| Colony Morphology | |||
|---|---|---|---|
| Code | Description | Code | Description |
| 1 | Colony color white, pale or transparent | 11 | Aerial mycelium felty, with mycelium cottony or wooly woven to form a compact surface |
| 2 | Colony color yellow, ochraceous, brown or others (even if partially) | 12 | Aerial mycelium floccose: with little tufts of hyphae |
| 3 | Reverse of Petri dish color unchanged | 13 | Colony lacunose, with depressions on the surface |
| 4 | Reverse of Petri dish color bleached | 14 | Aerial mycelium plumose, with tufts composed of a central hypha from which smaller hyphae branch off |
| 5 | Reverse of Petri dish color darkened | 15 | Aerial mycelium silky, with long and prostrate hyphae |
| 6 | Colony smooth and/or appressed and/or pellicular | 16 | Aerial mycelium subfelty; colony with a thin and prostrate mat, usually hardly visible |
| 7 | Aerial mycelium cottony, with hyphae spreading in all directions | 17 | Aerial mycelium velvety, with short and erected hyphae appressed together |
| 8 | Colony crusty, usually dark in color | 18 | Aerial mycelium wooly; colony matted with long hyphae or groups of hyphae |
| 9 10 | Aerial mycelium downy, with short, erected hyphae sparsely scattered Colony farinaceous in appearance | 19 | Colony mycelium submerged |
| Microscopic Characteristics | |||
| Code | Description | Code | Description |
| 20 | Hyphae with clamps at all septa | 28 | Cystidia in vegetative mycelium |
| 21 | Hyphae simple-septate | 29 | Short projection or protuberances on cell wall |
| 22 | Hyphae simple-septate with scattered or rare clamps | 30 | Oil or resinous drops on cell wall |
| 23 | Hyphae with thin cell wall | 31 | Hyphal knots or tangles |
| 24 | Hyphae with thick cell wall | 32 | Hyphal swellings |
| 25 | Hyphae with cells closely packed forming a pseudoparenchyma | 33 | Absence of conidia and/or blastoconidia and/or arthrospores and/or chlamydospores |
| 26 | Hyphae with numerous short branches, curved branches or thick-walled nodes | 34 | Presence of conidia and/or blastoconidia and/or arthrospores and/or chlamydospores |
| 27 | Encrusted hyphae or hyphae with crystals | 35 | Presence of anastomosis/hyphal bridges |
| Species | Distribution | Information and References | Typical Trophic Niche |
|---|---|---|---|
| Candolleomyces candolleanus | Cosmopolitan | N-rich soil | |
| Cerrena caperata | Holotropical (neotropical+African) | Wood | |
| Cubamyces lactineus | Subcosmopolitan (neotropical) |
| Wood |
| Gloeophyllum striatum | Neotropical |
| Wood |
| Lentinus crinitus | Neotropical | Wood | |
| Panaeolus antillarum | Originally neotropical, now subcosmopolitan | N-rich litter | |
| Psilocybe cubensis | Neotropical | Manure/N-rich litter | |
| Pycnoporus sanguineus | Originally neotropical, now subcosmopolitan |
| Wood |
| Stereum gausapatum | Holarctic |
| Wood |
| Trametes villosa | Neotropical | Wood |
| Species | Culture Characteristics | Hyphal Width (µm) | Growth Rate (mm/day) | Photos of the Colonies in MEA | Notes | References |
|---|---|---|---|---|---|---|
| Candolleomyces candolleanus | 1,5,12,15, 16,21,23, 33 | 2.5–3 | 0.42 ± 0.06 | ![]() | Presence of hyphal bundles | |
| Cerrena caperata | 1,5,7,12, 20,23,26, 33 | 1.5–5 | 0.37 ± 0.06 | ![]() | [63,64] | |
| Cubamyces lactineus | 1,5,6,12, 21,23,27, 32,34 | 1–3 | 0.38 ± 0.11 | ![]() | [63] | |
| Gloeophyllum striatum | 1,2,3,6,9, 19,22,23, 24,26,34 | 1.5–4 | 0.1 ± 0.06 | ![]() | Rare chlamydospores | [63] |
| Lentinus crinitus | 1,2,5,15, 18,20,23, 24,31,34 | 1–5 | 0.55 ± 0.05 | ![]() | Presence of crystals in the agar medium | |
| Panaeolus antillarum | 1,3,8,9,12, 13,21,23, 24,25,32, 33 | 0.8–5 | 0.28 ± 0.06 | ![]() | Presence of hyphal bundles | |
| Psilocybe cubensis | 1,3,15,18, 20,23,33 | 1.5–3 | 0.21 ± 0.03 | ![]() | ||
| Pycnoporus sanguineus | 1,2,5,7,18, 20,23,32, 34 | 1.5–4 | 0.64 ± 0.08 | ![]() | Pigmented hyphae | [63,65] |
| Stereum gausapatum | 1,2,3,7, 11,18,22, 23,24,33 | 1.5–7.5 | 0.69 ± 0.42 | ![]() | Septa with quadruple clamps | [30,63,66,67] |
| Trametes villosa | 1,5,7,18, 20,23,26, 30,31,33 | 1.5–5 | 0.36 ± 0.11 | ![]() | [64] |
| Species | CBS | MUT | MUCL | LE-BIN/VKM | CABI |
|---|---|---|---|---|---|
| Candolleomyces candolleanus | 13 | 5 | 0 | 4 | 0 |
| Cerrena caperata | 1 | 0 | 0 | 0 | 0 |
| Cubamyces lactineus | 1 | 0 | 0 | 0 | 0 |
| Gloeophyllum striatum | 2 | 0 | 5 | 0 | 0 |
| Lentinus crinitus | 1 | 0 | 3 | 0 | 0 |
| Panaeolus antillarum | 0 | 0 | 0 | 0 | 0 |
| Psilocybe cubensis | 4 | 1 | 2 | 3 | 0 |
| Pycnoporus sanguineus | 7 | 0 | 98 | 0 | 4 |
| Stereum gausapatum | 5 | 1 | 2 | 1 | 0 |
| Trametes villosa | 2 | 0 | 0 | 0 | 0 |
Disclaimer/Publisher’s Note: The statements, opinions and data contained in all publications are solely those of the individual author(s) and contributor(s) and not of MDPI and/or the editor(s). MDPI and/or the editor(s) disclaim responsibility for any injury to people or property resulting from any ideas, methods, instructions or products referred to in the content. |
© 2025 by the authors. Licensee MDPI, Basel, Switzerland. This article is an open access article distributed under the terms and conditions of the Creative Commons Attribution (CC BY) license (https://creativecommons.org/licenses/by/4.0/).
Share and Cite
Buratti, S.; Girometta, C.E.; Goppa, L.; Picozzi, C.; Rossi, P.; Savino, E.; Gargano, M.L.; Venturella, G.; Gugliotta, A.d.M.; Vitali, V.M.V.; et al. Culture Collections for Conservation Ex Situ: Characterization and Biotechnological Application Potential of Saprotrophic Fungal Strains from Brazil. Conservation 2025, 5, 70. https://doi.org/10.3390/conservation5040070
Buratti S, Girometta CE, Goppa L, Picozzi C, Rossi P, Savino E, Gargano ML, Venturella G, Gugliotta AdM, Vitali VMV, et al. Culture Collections for Conservation Ex Situ: Characterization and Biotechnological Application Potential of Saprotrophic Fungal Strains from Brazil. Conservation. 2025; 5(4):70. https://doi.org/10.3390/conservation5040070
Chicago/Turabian StyleBuratti, Simone, Carolina Elena Girometta, Lorenzo Goppa, Claudia Picozzi, Paola Rossi, Elena Savino, Maria Letizia Gargano, Giuseppe Venturella, Adriana de Mello Gugliotta, Vera Maria Valle Vitali, and et al. 2025. "Culture Collections for Conservation Ex Situ: Characterization and Biotechnological Application Potential of Saprotrophic Fungal Strains from Brazil" Conservation 5, no. 4: 70. https://doi.org/10.3390/conservation5040070
APA StyleBuratti, S., Girometta, C. E., Goppa, L., Picozzi, C., Rossi, P., Savino, E., Gargano, M. L., Venturella, G., Gugliotta, A. d. M., Vitali, V. M. V., & Rollini, M. (2025). Culture Collections for Conservation Ex Situ: Characterization and Biotechnological Application Potential of Saprotrophic Fungal Strains from Brazil. Conservation, 5(4), 70. https://doi.org/10.3390/conservation5040070